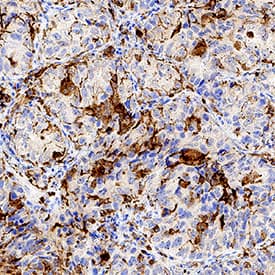
SR-AI/MSR antibody in Human Lung Tissue by Immunohistochemistry (IHC-P).

Human SR-AI/MSR Antibody
R&D Systems, part of Bio-Techne | Catalog # AF2708


Key Product Details
Validated by
Species Reactivity
Validated:
Cited:
Applications
Validated:
Cited:
Label
Antibody Source
Product Specifications
Immunogen
Lys77-Leu451
Accession # P21757
Specificity
Clonality
Host
Isotype
Endotoxin Level
Scientific Data Images for Human SR-AI/MSR Antibody
Detection of Human SR‑AI/MSR by Western Blot.
Western blot shows lysates of THP-1 human acute monocytic leukemia cell line untreated (-) or treated (+) with PMA. PVDF membrane was probed with 0.2 µg/mL of Goat Anti-Human SR-AI/MSR Antigen Affinity-purified Polyclonal Antibody (Catalog # AF2708) followed by HRP-conjugated Anti-Goat IgG Secondary Antibody (Catalog # HAF017). A specific band was detected for SR-AI/MSR at approximately 80 kDa (as indicated). This experiment was conducted under reducing conditions and using Immunoblot Buffer Group 1.SR‑AI/MSR in THP-1 Human Cell Line.
SR-AI/MSR was detected in immersion fixed THP-1 human acute monocytic leukemia cell line untreated (right panel) and treated with PMA (left panel) using Goat Anti-Human SR-AI/MSR Antigen Affinity-purified Polyclonal Antibody (Catalog # AF2708) at 1.7 µg/mL for 3 hours at room temperature. Cells were stained using the NorthernLights™ 557-conjugated Anti-Goat IgG Secondary Antibody (red; Catalog # NL001) and counterstained with DAPI (blue). Specific staining was localized to cytoplasm. View our protocol for Fluorescent ICC Staining of Non-adherent Cells.SR-AI/MSR in Human Lung Tissue.
SR-AI/MSR was detected in immersion fixed paraffin-embedded sections of human lung tissue using Goat Anti-Human SR-AI/MSR Antigen Affinity-purified Polyclonal Antibody (Catalog # AF2708) at 1 µg/mL for 1 hour at room temperature followed by incubation with the Anti-Goat IgG VisUCyte™ HRP Polymer Antibody (Catalog # VC004). Tissue was stained using DAB (brown) and counterstained with hematoxylin (blue). Specific staining was localized to macrophages. View our protocol for IHC Staining with VisUCyte HRP Polymer Detection Reagents.Applications for Human SR-AI/MSR Antibody
Blockade of Receptor-ligand Interaction
Immunocytochemistry
Sample: Immersion fixed THP‑1 human acute monocytic leukemia cell line
Immunohistochemistry
Sample: Immersion fixed paraffin-embedded sections of human lung tissue
Western Blot
Sample: THP‑1 human acute monocytic leukemia cell line treated with PMA
Formulation, Preparation, and Storage
Purification
Reconstitution
Formulation
Shipping
Stability & Storage
- 12 months from date of receipt, -20 to -70 °C as supplied.
- 1 month, 2 to 8 °C under sterile conditions after reconstitution.
- 6 months, -20 to -70 °C under sterile conditions after reconstitution.
Background: SR-AI/MSR
The type I class A macrophage scavenger receptor (SR-AI; also MSR-AI) is a 70-80 kDa protein that belongs to an ever expanding family of transmembrane molecules collectively referred to as scavenger receptors (1-3). Receptors of this family contain characteristic extracellular domains and bind to a series of generally unrelated, but negatively-charged/polyanionic ligands (1, 3). Human SR-AI is a type II transmembrane glycoprotein that is 451 amino acids (aa) in length. It contains a 50 aa cytoplasmic tail, a 26 aa transmembrane segment and a 375 aa extracellular region (4, 5). The extracellular region contains four definitive domains, with a membrane proximal spacer of 33 aa, an alpha-helical coiled-coil domain of 163 aa, a collagen-like domain of 69 aa, and a cysteine-rich C-terminus of 110 aa (4, 6). The cysteine-rich domain (CRD) forms three intrachain disulfide bonds (7). The functional form of the molecule is a 220-230 kDa membrane-associated trimer that, in human, apparently has two disulfide bonded chains and a third noncovalently associated subunit (8, 9). Human extracellular region is 73% and 72% aa identical to bovine and mouse SR-AI extracellular region, respectively. The human gene for SR-A gives rise to three isoforms; the I isoform of 451 aa, the II isoform of 358 aa, and the III isoform of 388 aa (4, 5, 10). All are equal through the first 344 aa which includes the cytoplasmic tail through the collagenous domain. Isoform II (SR-AII) shows a severe truncation of the CRD, but is expressed on the cell surface. Isoform III (SR-AIII) has a modest truncation of the CRD, and cannot be expressed on the cell surface. Their functions are unknown. However, relative to SR-AI, SR-AII is known to show differential sensitivity to LPS and receptor binding to gram-negative bacteria (9, 11), while SR-AIII is known to be a dominant-negative isoform (10). SR-AIII may achieve this by either heterotrimerizing with SR-AI, or simply eliminating the production of SR-AI mRNA.
References
- Platt, N. and S. Gordon (2001) J. Clin. Invest. 108:649.
- Linton, M.F. and S. Fazio (2001) Curr. Opin. Lipidol. 12:489.
- Platt, N. and S. Gordon (1998) Chem. Biol. 5:R193.
- Matsumoto, A. et al. (1990) Proc. Natl. Acad. Sci. USA 87:9133.
- Emi, M. et al. (1993) J. Biol. Chem. 268:2120.
- Naito, M. et al. (1992) Am. J. Pathol. 141:591.
- Resnick, D. et al. (1996) J. Biol. Chem. 271:26924.
- Ashkenas, J. et al. (1993) J. Lipid Res. 34:983.
- Penman, M. et al. (1991) J. Biol. Chem. 266:23985.
- Gough, P.J. et al. (1998) J. Lipid Res. 39:531.
- Peiser, L. et al. (2000) Inf. Immun. 68:1953.
Long Name
Alternate Names
Gene Symbol
UniProt
Additional SR-AI/MSR Products
Product Documents for Human SR-AI/MSR Antibody
Product Specific Notices for Human SR-AI/MSR Antibody
For research use only